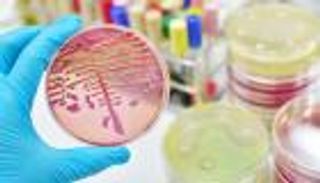
عدو الشباب والأطفال.. "المرض النادر" يعود للظهور

طريق السويد لـ"الناتو" مفخخ في الجانبين.. تظاهرات داخلية

يوما بعد يوم، يتعقد طريق السويد إلى حلف شمال الأطلسي "الناتو" داخليا وخارجيا، رغم تفاؤل قيادات التكتل العسكري.
وتظاهر المئات في وسط ستوكهولم، الأحد، احتجاجا على ترشح السويد لعضوية حلف شمال الأطلسي (ناتو) وإقرارها قانونا جديدا لمكافحة الإرهاب، رغم مطالبة تركيا بحظر التظاهرة.
وقال المتحدث باسم "التحالف ضد الناتو" توماس بيترسون لوكالة "فرانس برس"، أثناء الاحتجاج "إنهم يلاحقون الأكراد في السويد".
وأضاف أن الفكرة من القانون هي "الاعتقال والمحاكمة" حتى يسمح الرئيس التركي رجب طيب أردوغان "للسويد بالانضمام إلى الناتو".
والقانون الجديد الذي دخل حيز التنفيذ في الأول من يونيو/حزيران يجرم "الانخراط في منظمة إرهابية"، ويأتي ضمن جهود السويد لتعزيز تشريعات مكافحة الإرهاب، وهو مطلب تركي رئيسي للموافقة على عضوية ستوكهولم في الناتو.
وأعربت أنقرة عن استيائها في وقت سابق من هذا الأسبوع بشأن الاحتجاج الذي جرى تحت شعار "لا للناتو، لا لقوانين أردوغان في السويد"، والذي نظمته مجموعات مقربة من حزب العمال الكردستاني المحظور في تركيا.
وشوهد الأحد متظاهرون يلوحون بالعديد من أعلام حزب العمال الكردستاني إلى جانب لافتات كتب عليها "لا للناتو".
من جهته، قال متحدث باسم الرئاسة التركية الثلاثاء إن "من غير المقبول تماما أن يواصل إرهابيو حزب العمال الكردستاني النشاط بحرية في السويد"، مطالبا السلطات السويدية بمنعهم من التظاهر.
ورغم أن حزب العمال الكردستاني مصنف أيضًا منظمة إرهابية في السويد - كما هي الحال في بقية الاتحاد الأوروبي - إلا أنه يُسمح عمومًا لمؤيديه بالاحتجاج علنًا.
إلى ذلك، أكد وزير العدل السويدي الجمعة الماضي، أن القانون الجديد لا يهدف إلى تقييد حرية التعبير.
أما وزير الخارجية السويدي توبياس بيلستروم فأشاد الخميس الماضي، بالتشريع الجديد باعتباره الخطوة الأخيرة للسويد بموجب اتفاق أبرم مع تركيا العام الماضي لكي تصادق أنقرة على عضوية ستوكهولم.
وقال فيلغوت كارلسون من منظمة البديل الاشتراكي الدولي لوكالة "فرانس برس" أثناء الاحتجاج، اليوم "الحقيقة أن القانون مكتوب بعبارات فضفاضة، إنه غامض للغاية".
وبعد لقائه أردوغان في تركيا، أمس، دعا الأمين العام لحلف شمال الأطلسي ينس ستولتنبرغ أنقرة، إلى التراجع عن معارضتها لترشح السويد، قائلاً إن ستوكهولم عالجت المخاوف الأمنية.
وأعيد انتخاب أردوغان لولاية أخرى في 28 مايو/أيار، وهو لا يزال يعارض عضوية السويد متهمًا إياها بإيواء نشطاء أكراد تعتبرهم تركيا "إرهابيين".
وأشار ستولتنبرغ اليوم، إلى أن "الوقت حان ليحدث ذلك (الانضمام) قبل قمة فيلنيوس" المقررة في 11 و12 يوليو/تموز، عندما يجتمع رؤساء دول "الناتو" الـ 31.
وأعلن ستولتنبرغ إنشاء "آلية دائمة" بين حلف شمال الأطلسي وتركيا وعقد اجتماع مقبل "في 12 يونيو/حزيران" من دون تحديد مكان انعقاده.